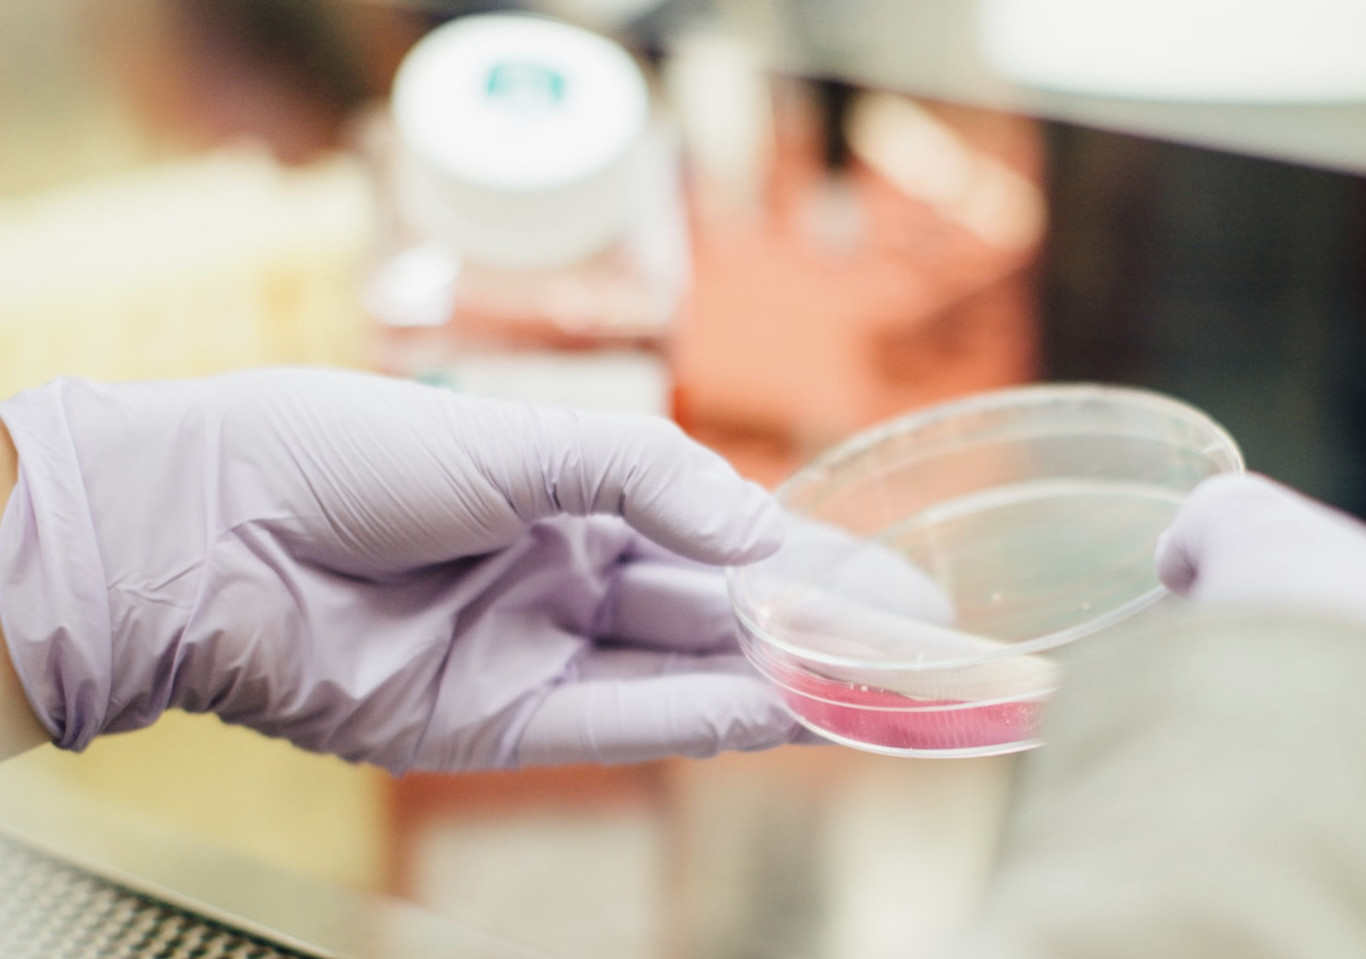

La madre de todos los estudios sobre el cáncer que tenemos hasta la fecha. Un meta-análisis en el que se han analizado los genomas de más de 2.600 pacientes con cáncer en todo el mundo nos muestra la imagen más completa que […]
cancer
Un innovador estudio pone sobre la mesa una nueva técnica capaz de eliminar selectivamente las células tumorales sin dañar otras sanas. Esta todavía está en sus primeras fases de desarrollo. No obstante, puesto que la técnica con ultrasonidos ya es conocida desde hace […]
El innovador tratamiento desarrollado por Nanogap, recibe un premio internacional Piense en un cabello. Tiene un espesor aproximado de medio millón de átomos. Pues imagine ahora algo mucho más insignificante, con un grosor 170.000 veces más pequeño aún. Cuesta creerlo, pero […]
Hace unos días, frente al Monumento de Abraham Lincoln, el Presidente Trump se comprometía a «plantar la bandera norteamericana en Marte pronto«. Insisto en lo de «pronto» porque no es la primera vez que lo dice. Sin embargo, no hemos avanzando demasiado en […]
Las vacunas son uno de los mejores inventos de los últimos siglos. Se estima que han podido salvar unos 1.500 millones de vidas desde que se aplican. Ahora, tras el florecimiento de la genómica, vuelven a postularse como solución a una de […]
¿Qué pasaría si los modelos de aprendizaje profundo pudieran detectar el cáncer en las primeras etapas del mismo con mayor precisión que un radiólogo veterano? La tasa de supervivencia de los pacientes de cáncer en caso de detección temprana suele ser alta (en […]
Cuando una maquinaria o instrumentos profesionales son controlados por software, sea cual sea el sector, siempre existe riesgo de que un malware lo infecte. Y es justo lo que han intentado y conseguido con éxito un grupo de investigadores de la Universidad […]
- - Publicidad -
Artículos más vistos
Divulgadores del Misterio en YouTube
ÚLTIMOS ARTÍCULOS
Twitter